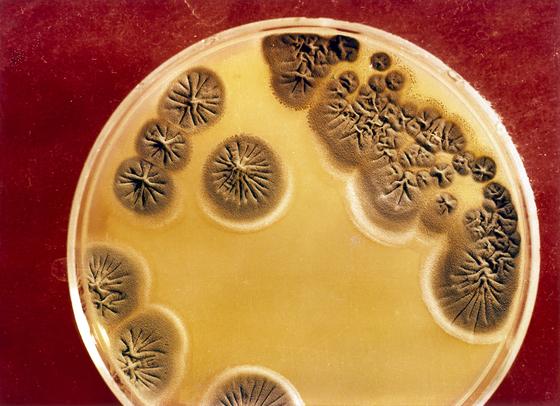

Teixobactin: Wirkstoff gegen gefährlichen Krankenhauskeim MRSA gefunden
Der antibiotikaresistente Krankenhauskeim MRSA hat einen neuen Gegner: Bonner Forscher haben gemeinsam mit US-Kollegen im Erdreich den Wirkstoff Teixobactin gefunden. Er könnte sich als neues Wunder-Antibiotikum entpuppen.
Pilzkultur in einer Petri-Schale: Infektionskrankheiten werden mächtiger, wenn die Bakterien gegen Antibiotika Resistenzen bilden. Forscher suchen deswegen nach neuen Wirkstoffen im Erdreich – und haben Teixobactin gefunden.
Foto: dpa
Das Wundermittel Antibiotikum verliert seine Wirkung: Oftmals falsch und zu viel eingesetzt, haben sich zwischenzeitlich zahlreiche Keime daran gewöhnt und Resistenzen gebildet. Umso wichtiger ist die Entdeckung eines US-amerikanischen Forscherteams, zu dem auch Mitarbeiter des Institutes für medizinische Mikrobiologie, Immunologie und Parasitologie der Universitätsklinik Bonn gehören.
Die Wissenschaftler haben 10.000 verschiedene Stämme von Bodenbakterien aus dem Erdreich analysiert. Sie untersuchten gebildete Stoffe auf ihre antimikrobielle Wirkung hin, stießen dabei auf das Bodenbakterium Elefhtheria terrae und isolierten einen Wirkstoff namens Teixobactin.
Teixobactin zerstört die Schutzhülle krankmachender Bakterien
Teixobactin bekämpft krankmachende Bakterien anders als gängige Antibiotika, die Eiweiße der Keime angreifen, vor Mutationen und Resistenzen aber oft resignieren müssen. Der Wirkstoff greift die Schutzhülle der Bakterien an, so dass diese nicht überleben können. Ähnlich funktionierte auch schon das 1953 entdeckte Antibiotikum Vancomycin.
Die US-amerikanische Genetikerin Losee Ling und ihr Team der US-amerikanischen Pharmafirma NovoBiotic testeten Teixobactin bereits erfolgreich an infizierten Mäusen. Der Wirkstoff zeigte erste Wirkung gegen den Krankheitserreger Staphylococcus aureus, zu dem auch der gefährliche Krankenhauskeim MRSA zählt. Diesen konnten die Wissenschaftler im Labor keine Resistenzen entwickeln lassen, obwohl sie über mehrere Wochen minimale Mengen des Antibiotikums zugaben.

Antibiotika-Resistenzen bilden sich insbesondere dort, wo viele Antibiotika im Umlauf sind – etwa in Krankenhäusern und in der Massentierhaltung. Dort überträgt sich die Resistenz dann durch Gentransfer auf andere Bakterienstämme.
Quelle: Daniel Reinhardt/dpa
Diese Beobachtung macht den Forschern große Hoffnung. Teixobactin scheint ähnlich stark zu sein wie das Antibiotikum Vancomycin, gegen das Krankheitserreger erst nach 30 Jahren erste Resistenzen gebildet hatten. Diese bilden sich insbesondere dort, wo viele Antibiotika im Umlauf sind – etwa in Kliniken und in der Massentierhaltung. Dort vermehren sich die Krankheitserreger und übertragen die Resistenz durch Gentransfer auf andere Bakterienstämme.
Bis zur Zulassung könnten noch zehn Jahre vergehen
Die Forscher vermuten, dass im Erdreich noch weitere solcher potentielle Antibiotika zu finden sind. „Die Natur biete ein großes Reservoir an weiteren potenziellen Antibiotika“, betont das Team um Kim Lewis von der Bostoner Northeastern University im Fachmagazin Nature. „Die Eigenschaften dieser Verbindungen zeigen einen Weg zur Entwicklung von Antibiotika, die die Bildung von Resistenzen wahrscheinlich vermeiden.“ Doch bis zur Zulassung von Teixobactin wird bestimmt noch ein Jahrzehnt vergehen. Zunächst muss der Wirkstoff die klinischen Prüfungen bestehen.
Ein Beitrag von: